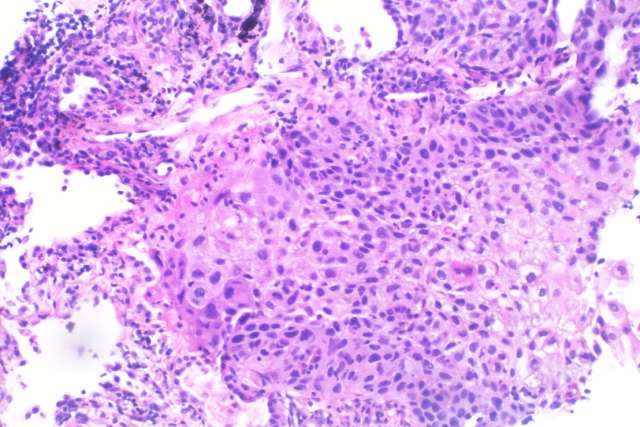
Histopathology of squamous cell carcinoma of the lung

Four proposed state-of-the art image search engines for automating search and retrieval of digital histopathology slides were found to be of inadequate performance for routine clinical care, new research suggests.
The performance of the artificial intelligence algorithms to power the histopathology image databases was worse than expected, with some having less than 50% accuracy, which is not suitable for clinical practice, said Dr. Helen Shang, a third-year internal medicine resident and incoming hematology-oncology fellow at the David Geffen School of Medicine at UCLA.
“Currently, there are many AI algorithms being developed for medical tasks but there are fewer efforts directed on rigorous, external validations,” said Shang, who co-led the study with Dr. Mohammad Sadegh Nasr of the University of Texas at Arlington. “The field has also yet to standardize how AI algorithms should be best tested prior to clinical adoption.”
The paper is published in the peer-reviewed journal NEJM AI.
As it now stands, pathologists manually search and retrieve histopathology images, which is very time consuming. As result, there has been growing interest in developing automated search and retrieval systems for the digitized cancer images.
The researchers designed a series of experiments to evaluate the accuracy of search engine results on tissue and subtype retrieval tasks on real-world UCLA cases and larger, unseen datasets. The four engines examined are Yottixel, SISH, RetCCL, HSHR. Each takes a different approach toward indexing, database generation, ranking and retrieval of images.
Overall, the researchers found inconsistent results across the four algorithms – for instance, Yottixel performed best on breast tissue, while RetCCL had the highest performance on brain tissue. They also found that a group of pathologists found search engine results to be of low to average quality with several visible errors.
The researchers are devising new guidelines to standardize the clinical validation of AI tools, Shang said. They are also developing new algorithms that leverage a variety of different data types to develop more reliable and accurate predictions.
“Our studies show that despite amazing progress in artificial intelligence over the past decade, significant improvements are still needed prior to widespread uptake in medicine,” Shang said. “These improvements are essential in order to avoid doing patients harm while maximizing the benefits of artificial intelligence to society.”
The study’s additional authors are Dr. Chace Moleta and Dr. Jitin Makker of UCLA, and, Jai Prakash Veerla, Jillur Rahman Saurav, Amir Hajighasemi, Parisa Boodaghi Malidarreh, Manfred Huber, and Jacob Luber, Ph.D of the University of Texas at Arlington.
The study was funded by the University of Texas System Rising STARs Award and the CPRIT First Time Faculty Award.